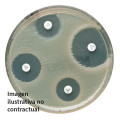
Netilmicina NET30

- +54 11 4568-4022
- +54 9 11 5645-0095
- Lun-Vie de 9:00 a 17:00
Buscador de productos
Oxoid Ltd


Una de las compañías líderes mundiales en la elaboración de medios de cultivo para microbiología y reactivos de diagnóstico. Los productos se utilizan en laboratorios clínicos e industriales para el aislamiento e identificación de bacterias u otros microorganismos causantes de enfermedades o deterioro.
Visitar sitio web Oxoid Limited
Bioartis SRL tiene certificado su sistema de gestión de la calidad por IRAM, según norma IRAM-ISO 9001:2015 con número de registro RI 9000-3818